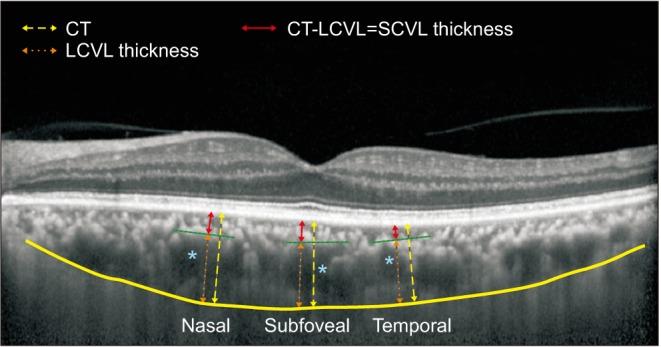
https://cdn.ncbi.nlm.nih.gov/pmc/blobs/fe7a/6305867/306831e6d305/wjmh-37-85-g001.jpg

勃起功能障碍患者的脉络膜厚度分析
Choroidal Thickness Analysis in Patients with Erectile Dysfunction.
作者信息
Kim Yong Kyu, Lee Jang Hoon, Park Sung Pyo, Yang Dae Yul
机构信息
Department of Ophthalmology, Kangdong Sacred Heart Hospital, Hallym University College of Medicine, Seoul, Korea.
Department of Urology, Kangdong Sacred Heart Hospital, Hallym University College of Medicine, Seoul, Korea.
出版信息
World J Mens Health. 2019 Jan;37(1):85-92. doi: 10.5534/wjmh.180038.
PURPOSE
To investigate the morphological features of choroidal vasculature in patients with erectile dysfunction (ED) by analyzing choroidal thickness using optical coherence tomography.
MATERIALS AND METHODS
We enrolled 39 patients with ED and 19 controls. ED was defined as an erectile function domain score <26 on the International Index of Erectile Function (IIEF) questionnaire. Small-choroidal-vessel-layer (SCVL) thickness was calculated by subtracting large-choroidal-vessel-layer (which corresponded to Haller's layer) thickness from total choroidal thickness. Choroidal thickness was compared between the ED and control groups.
RESULTS
SCVL thickness was lesser in the ED group than in the control group (control, 69.8±24.3 μm ED, 55.1±19.9 μm; p=0.017). Among patients without diabetes, the ED group showed significantly lesser SCVL thickness than did the control group (control, 77.1±22.7 μm ED, 56.5±20.9 μm; p=0.021). However, among patients with diabetes, choroidal thickness showed no significant intergroup difference. Multiple linear regression analysis revealed that spherical equivalent (standardized coefficient β=0.294; p=0.019) and the IIEF erectile function score (standardized coefficient β=0.315; p=0.012) were significantly associated with SCVL thickness.
CONCLUSIONS
SCVL thickness, including the choriocapillaris layer and medium-sized choroidal vascular layer, decreased in proportion to ED severity, suggesting that microvascular changes in choroidal vessels may occur before specific ocular diseases in patients with ED.
目的
通过光学相干断层扫描分析脉络膜厚度,研究勃起功能障碍(ED)患者脉络膜血管的形态学特征。
材料与方法
我们纳入了39例ED患者和19例对照。ED定义为国际勃起功能指数(IIEF)问卷中勃起功能领域得分<26。小脉络膜血管层(SCVL)厚度通过从脉络膜总厚度中减去大脉络膜血管层(对应于哈勒层)厚度来计算。比较ED组和对照组之间的脉络膜厚度。
结果
ED组的SCVL厚度低于对照组(对照组,69.8±24.3μm;ED组,55.1±19.9μm;p = 0.017)。在无糖尿病的患者中,ED组的SCVL厚度显著低于对照组(对照组,77.1±22.7μm;ED组,56.5±20.9μm;p = 0.021)。然而,在糖尿病患者中,脉络膜厚度在组间无显著差异。多元线性回归分析显示,球镜等效度(标准化系数β = 0.294;p = 0.019)和IIEF勃起功能评分(标准化系数β = 0.315;p = 0.012)与SCVL厚度显著相关。
结论
包括脉络膜毛细血管层和中等大小脉络膜血管层的SCVL厚度与ED严重程度成比例降低,提示ED患者在特定眼部疾病发生之前可能已出现脉络膜血管的微血管变化。